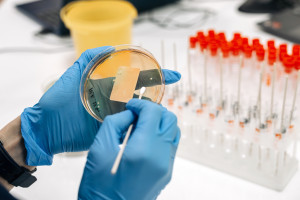
Olbrzymi zbiór danych o mikrobiomie Polaków trafi do zastosowań rynkowych

NEWSLETTER
Zamów newsletter z najciekawszymi i najlepszymi tekstami portalu.
Autorzy: PAP; oprac. AG • Źródło: PAP • Opublikowano: 13 listopada 2025 06:54 • Zaktualizowano: 13 listopada 2025 07:24
Zapalenie płuc pozostawało w zeszłym roku najpoważniejszą zakaźną przyczyną śmierci na świecie, zabijając około 1,23 mln osób – poinformowała w środę Światowa Organizacja Zdrowia (WHO) w dorocznym raporcie.

Blanscape / Shutterstock
- W 2024 roku zapaleniem płuc zaraziło się 10,7 mln osób - 2 proc. mniej w porównaniu do roku poprzedniego
- Liczba zgonów z powodu zapalenia płuc spadła, jednak wciąż pozostaje ono najpoważniejszą zakaźną przyczyną śmierci na świecie
- Eksperci podkreślają, że trzeba zwiększyć nakłady finansowe na walkę z tą uleczalną, ale dla milionów ludzi wciąż śmiertelną chorobą
Zapalenie płuc jest uleczalne, ale wciąż zabija
WHO szacuje, że w zeszłym roku zapaleniem płuc zaraziło się 10,7 mln osób: 5,8 mln mężczyzn, 3,7 mln kobiet i 1,2 mln dzieci.
Liczba zgonów na zapalenie płuc spadła w zeszłym roku w porównaniu z 2023 r. o 3 proc., zaś samych zakażeń było mniej o 2 proc.
— Cięcia budżetowe i utrzymujące się czynniki epidemiczne grożą zniweczeniem tych osiągniętych ciężką pracą postępów, ale dzięki zaangażowaniu politycznemu, wspieraniu inwestycji i międzynarodowej solidarności możemy odwrócić tendencję i wyeliminować raz na zawsze tę prastarą plagę — podkreśliła szefowa wydziału HIV, zapalenia płuc, żółtaczki i chorób przekazywanych drogą płciową w WHO Tereza Kasaeva.
Od 2020 r. suma przeznaczana na walkę z zapaleniem płuc utrzymuje się na stałym poziomie i wynosiła w zeszłym roku 5,9 mld dolarów (na zapobieganie, diagnostykę i leczenie). Jest to kwota dużo niższa od potrzeb, szacowanych na 22 mld dol. rocznie do 2027 r.
Zapalenie płuc jest chorobą uleczalną. Powoduje je bakteria przenoszona drogą kropelkową, gdy chory kicha, kaszle lub pluje.
Dowiedz się więcej na temat:

 2 miesięcy temu
31
2 miesięcy temu
31

English (US) ·
English (US) ·  Polish (PL) ·
Polish (PL) ·